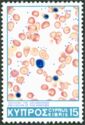
Prevention of Thalassaemia

Stamp catalog [Theme: Healthcare | Year: 1978 | Printer: None] [1/5] : Colnect 📮
Easily manage your personal collection - Log In
Stamp catalog › Stamps (Year: 1978, Printer: None)
Medicine
- Country:
- Albania
- Series:
- Socialism Activities
- Catalog codes:
- Mi:AL L1942, Sn:AL 1932A, Yt:AL 1743L, Sg:AL 1988, AFA:AL 1956
- Themes:
- Children | Healthcare | Medicines | Microscopes | Professions
- Issued on:
- 1978
- Colors:
- Multicolor
- Format:
- Stamp
- Emission:
- Definitive
- Perforation:
- comb 12½ x 12
- Printing:
- Offset lithography
- Face value:
- 3 Lek - Albanian lek
- Score:
- 67% Accuracy: Medium
- Buy Now:
- 2 sale offers from US$ 0.29
World Congress of the Int. League supporting Mental Disabled
- Country:
- Austria
- Catalog codes:
- from colnect.com
- Has minor variants: 1
- Themes:
- Conferences | Disabled | Healthcare
- Issued on:
- 1978-10-02
- Expiry date:
- 2002-06-30
- Size:
- 39 x 30 mm
- Colors:
- Multicolor
- Designers:
- Otto Stefferl
- Format:
- Stamp
- Emission:
- Commemorative
- Perforation:
- comb 13¾ x 14¼
- Printing:
- Photogravure
- Face value:
- 6 öS - Austrian schilling
- Print run:
- 3,200,000
- Score:
- 12% Accuracy: Very High
- Related items:
- 4 (See)
- Buy Now:
- 36 sale offers from US$ 0.05
Graphic Representation - World Hypertension Month
- Country:
- Belgium
- Series:
- Philanthropic Edition
- Catalog codes:
- Mi:BE 1934, Sn:BE B964, Yt:BE 1877, Sg:BE 2518, AFA:BE 1941, Bel:BE 1882, Un:BE 1877
- Has minor variants: 1
- Themes:
- Healthcare | Measuring Instruments | Philanthropist
- Issued on:
- ColnectIsBest
- Colors:
- Multicolor
- Designers:
- Jean Malvaux (E) | Oscar Bonnevalle
- Format:
- Stamp
- Emission:
- Semi-Postal
- Perforation:
- comb 11½
- Printing:
- Photogravure
- Face value:
- 6+3 fr - Belgian franc
- Print run:
- 850,685
- Score:
- 35% Accuracy: Very High
- Related items:
- 3 (See)
- Buy Now:
- 4 sale offers from US$ 0.18
Sanatorium "De Mick" - Brasschaat
- Country:
- CopyWrong
- Series:
- ColnectScrp
- Catalog codes:
- Mi:BE 1935, Sn:BE B965, Yt:BE 1878, Sg:BE 2519, AFA:BE 1942, Bel:BE 1883, Un:BE 1878
- Has minor variants: 1
- Themes:
- CopyWrong
- Issued on:
- 1978-02-18
- Colors:
- CopyWrong
- Designers:
- iInfringe
- Format:
- iInfringe
- Emission:
- ColnectScrp
- Perforation:
- VisitColnectCom
- Printing:
- VisitColnectCom
- Face value:
- iInfringe
- Print run:
- VisitColnectCom
- Score:
- CopyWrong
- Related items:
- iInfringe
- Buy Now:
- iInfringe
Heart, 4 Arrows, WHO Emblem
- Country:
- Bulgaria
- Series:
- The Fight against High Blood Pressure
- Catalog codes:
- iInfringe
- Themes:
- Healthcare | W.H.O.
- Issued on:
- iInfringe
- Size:
- 45 x 30 mm
- Colors:
- Multicolor
- Format:
- Stamp
- Emission:
- Commemorative
- Perforation:
- comb 13
- Printing:
- Photogravure
- Face value:
- 23 ст - Bulgarian stotinka
- Print run:
- 200,000
- Score:
- 60% Accuracy: High
- Buy Now:
- 2 sale offers from US$ 0.47
Prevention of Thalassaemia
- Country:
- Cyprus
- Series:
- International Anniversaries and Events
- Catalog codes:
- Mi:CY 492, Sn:CY 504, Yt:CY 487, Sg:CY 511, Un:CY 487
- Themes:
- Healthcare
- Issued on:
- 1978-10-23
- Size:
- 27 x 40 mm
- Colors:
- Multicolor
- Format:
- Stamp
- Emission:
- Commemorative
- Perforation:
- comb 13¼ x 14
- Printing:
- Offset lithography
- Face value:
- 15 M - Cypriot mil
- Print run:
- 613,625
- Score:
- 49% Accuracy: High
- Related items:
- 1 (See)
- Buy Now:
- 2 sale offers from US$ 0.29
Anti-cancer
- Country:
- Denmark
- Series:
- Anniversaries and Events 1978
- Catalog codes:
- iInfringe
- Themes:
- Anniversaries and Jubilees | Cancer (Disease) | Healthcare
- Issued on:
- 1978-10-12
- Size:
- 31 x 24 mm
- Colors:
- Red
- Designers:
- Arne Kühlmann (E) | Claus Achton Friis
- Format:
- Stamp
- Emission:
- Semi-Postal
- Perforation:
- comb 12¾
- Printing:
- Recess
- Face value:
- 120+20 øre - Danish øre
- Print run:
- 2,155,050
- Score:
- 30% Accuracy: Very High
- Related items:
- 1 (See)
- Description:
- 50th Anniversary Danish Cancer Campaign
- Buy Now:
- 5 sale offers from US$ 0.04
Dominican League Against Cancer
- Country:
- VisitColnectCom
- Series:
- ColnectIsBest
- Catalog codes:
- CopyWrong
- Themes:
- from colnect.com
- Issued on:
- 1978-10-02
- Size:
- from colnect.com
- Colors:
- CopyWrong
- Format:
- ColnectScrp
- Emission:
- CopyWrong
- Perforation:
- iInfringe
- Printing:
- VisitColnectCom
- Face value:
- CopyWrong
- Score:
- ColnectScrp
- Description:
- with year 1977
- Buy Now:
- iInfringe
Eradication of smallpox
- Country:
- Egypt
- Catalog codes:
- Mi:EG 1284, Sn:EG 1077, Yt:EG 1050, Sg:EG 1357
- Themes:
- Diseases | Healthcare
- Issued on:
- 1978-04-07
- Colors:
- Multicolor
- Watermark:
- Eagle Multiple [Up]
- Format:
- Stamp
- Emission:
- Commemorative
- Perforation:
- comb 11½
- Printing:
- Photogravure
- Face value:
- 20 M - Egyptian millieme
- Score:
- 52% Accuracy: Medium
- Buy Now:
11th Greek Surgery Congress
- Country:
- Greece
- Series:
- Anniversaries and Events (1978)
- Catalog codes:
- iInfringe
- Themes:
- Conferences | Healthcare | Medical Science | Physicians | Professions
- Issued on:
- 1978-09-21
- Size:
- 28 x 36 mm
- Colors:
- Multicolor
- Format:
- Stamp
- Emission:
- Commemorative
- Perforation:
- comb 12¾ x 12½
- Printing:
- Offset lithography
- Face value:
- 1.50 ₯ - Greek drachma
- Print run:
- 4,000,000
- Score:
- 24% Accuracy: Very High
- Related items:
- 6 (See)
- Buy Now:
- 3 sale offers from US$ 0.09